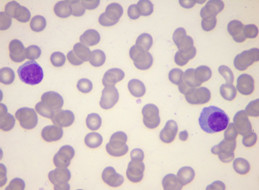
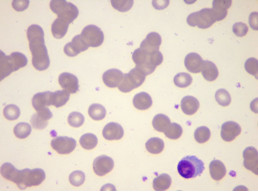
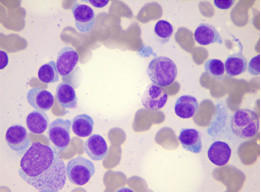

【检验临床面对面】一例极速进展的高龄原发性浆细胞白血病
作者:窦心灵,甘肃省酒泉市人民医院
病例简介
患者,女,82岁,因“间断性全身乏困无力,伴胸闷气短5月”入住我院血液科。患者无头晕、咳嗽、咳痰,无发热、畏寒、出汗、牙龈出血、鼻出血、皮肤紫癜,无皮肤黄染、骨关节疼痛。查体:T 36.5℃,神志清,精神差,全身皮肤粘膜未见黄染、紫癜、皮疹;全身浅表淋巴结未触及肿大;肝脾肋下未触及。
辅助检查
血常规(2018-08-03):WBC 9.77×10^9/L,NE 26.5%(↓),LY 43.1%,MO 30.2%(仪器分类),RBC 2.38×10^12/L(↓),HGB 70g/L(↓),NRBC 0.4%(↑),IG 1.2%(↑),PLT 169×10^9/L,Ret 2.1%(↑);血涂片镜下复检:可见约15%的浆系细胞(以原、幼浆细胞为主)、少量幼稚粒细胞及有核红细胞,成熟红细胞缗钱状排列。
尿常规:PRO 2+、BLD 2+、LEU 1+;镜检:WBC 1-3/HP、RBC 0-1/HP。
血生化:钙 1.75 mmol/L(↓),磷 2.28 mmol/L(↑),尿素 8.40 mmol/L(↑),肌酐 197.50μmol/L(↑),尿酸656.8μmol/L(↑),胱抑素-C 2.78mg/L(↑),β2-微球蛋白 13.87mg/L(↑),总蛋白 109.70g/L(↑),清蛋白 27.00g/L(↓),球蛋白82.70g/L(↑),A/G 0.33(↓)。
贫血四项:血清铁 11.89μmol/L,铁蛋白 218.50ng/mL,叶酸 52.56nmol/L(↑),维生素B12 274.00pmol/L。
血清免疫球蛋白:IgG 85.97g/L(↑),IgM 0.10g/L(↓),IgA 0.05g/L(↓)。
红细胞沉降率:>140mm/h。
外周血片(2018-08-03)所见如下:

外周血片 瑞-姬氏染色 1000X
骨髓涂片所见如下:

骨髓涂片 瑞-姬氏染色 1000X
骨髓及外周血分类比例如下:

形态学特征及诊断意见:

骨髓活检结果如下:

流式细胞术分析结果:


浆细胞富集(CD138)试验:

IGH基因重排检测(FISH)

血清免疫固定电泳结果:

血常规(2018-08-12):WBC 75.66×10^9/L(↑),NE 18.4%(↓),LY 55.3%(↑),MO 25.8%(仪器分类),RBC 2.42×10^12/L(↓),HGB 76g/L(↓),PLT 161×10^9/L;血涂片镜下复检:可见约63%的浆系细胞(其中原、幼浆细胞约为53%)及少量有核红细胞,成熟红细胞缗钱状排列。
外周血片(2018-08-12)所见如下:




外周血片 瑞-姬氏染色 1000X
综合诊断结论
原发性浆细胞白血病(IgG-κ型)
分析总结
浆细胞白血病(plasma cell leukemia,PCL),在造血与淋巴组织肿瘤WHO(2016)分类中归属于成熟B细胞肿瘤,是浆细胞骨髓瘤(PCM)的一个临床变型。Kyle等最早定义PCL,即外周血克隆性浆细胞占有核细胞的20%或以上,或绝对计数>2×10^9/L。根据临床上有无PCM病史,可将PCL分为原发性和继发性两大类。原发性浆细胞白血病(primary plasma cell leukerIlia,PPCL)发生于无PCM病史的患者,约占PCL的50%~70%;继发浆细胞白血病(secondary plasma cell leukemia,SPCL)则是PCM终末期的白血病阶段,约占PCL的30%~50%,仅占PCM的1%,也有少数可继发于WM、淋巴瘤、慢性淋巴细胞白血病和淀粉样变性。近年来,报道认为,Kyle的诊断标准过于严格,当外周血克隆性浆细胞占有核细胞的5%,或绝对计数>0.5×10^9/L时,若没有进行治疗,则很快将进展为PPCL。所以,降低诊断标准,结合流式细胞术检测肿瘤性浆细胞,应用DNA分析以及分子学标记,或许能早期识别PPCL,并通过早期干预从而改变其自然病程。
与PCM及SPCL相比,PPCL的发病年龄更为年轻化,中位发病年龄为53岁,男女比例接近。初诊PPCL患者的临床表现可兼有急性白血病及PCM的特点,贫血、骨痛、乏力、发热、出血等非特异性症状常见。除外周血和骨髓,肿瘤性浆细胞可浸润髓外组织,如脾脏、肝脏、胸膜渗出液、腹水和脑脊液中。白血病性浆细胞具有其他骨髓瘤的大多数形态变化,但常表现为许多浆细胞胞体小、胞浆较少,类似于浆细胞样淋巴细胞。PPCL存在高肿瘤负荷,PPCL骨髓浆细胞百分比(37%-100%)、血清乳酸脱氢酶、β2-微球蛋白、肌酐水平较PCM要高得多。PPCL的血清和尿蛋白电泳亦可发现单克隆免疫球蛋白,与IgG型及IgA型骨髓瘤相比,IgD型和IgE型骨髓瘤以白血病形式出现的比例较高。CD38和CD138在PPCL中几乎100%表达,但PPCL与PCM相比,表达CD27、CD56、CD71、CD117和HLA-DR减少,更多的表达CD20、CD44、CD45、CD19和CD23。异常核型更常见且多为非超二倍体(SPCL则多为超二倍体),其中染色体易位多涉及IGH(定位于14q32),17p-、13q-、1q+、1p-在PPCL中发生率明显高于MM,对预后不利的细胞基因的发生率高。PCL具有骨髓瘤的大多数症状,但溶骨性病损和骨痛较少见,而淋巴结肿大、器官增大和肾衰更常见。PCL是一个侵袭性疾病,生存期短。
该例患者发病年龄高,首次骨穿时骨髓浆细胞系比例达61.5%,以原始和幼稚浆细胞为主,形态亦符合白血病性浆细胞的特征,即浆细胞胞体小、胞浆较少,类似于浆细胞样淋巴细胞,但外周血浆系细胞比例为15%左右,绝对值亦<2×10^9/L,按现行诊断标准,尚未达到PCL诊断标准,形态学诊断意见暂考虑浆细胞骨髓瘤。然而该患者病情进展极为迅速,10天后复查血常规,WBC已达75.66×10^9/L,外周血涂片浆细胞系比例已达63%(其中原、幼浆细胞约为53%),绝对值为47.67×10^9/L,已达PCL诊断标准,因该患者无PCM病史,且病情进展极快,遂诊断为原发性浆细胞白血病(PPCL)。因此,对于无高钙血症和和骨病损,骨髓浆细胞系比例明显增高,外周血浆细胞比例临近20%的病例,一定要定期复查血常规和外周血涂片浆细胞比例,以防止漏诊早期PCL。
参考文献
1.王欢,李建勇,孙超.原发浆细胞白血病诊疗进展[J].中国实验血液学杂志,2017,
25(6):1837-1840.
2.周小鸽,陈辉树,主译.造血与淋巴组织肿瘤WHO分类.第4版[M].北京:诊断病理学杂志社,2011:398-406.

作者简介: 窦心灵,副主任检验师,君安医学细胞平台副总台长兼血液(骨髓)1台总台长,细胞形态学那些事微信群群主,检验视界网及君安医学细胞平台公众号特约作者。就职于甘肃省酒泉市人民医院检验科,从事血液病骨髓形态学及综合诊断工作十多年,先后在中国医学科学院血液学研究所、甘肃省人民医院及宁夏医科大学总医院进修学习。主持完成酒泉市科技进步奖3项,发表检验医学及血液病学相关专业论文十余篇,参编《医学细胞彩色图谱》专著1本。2004年和2008年分别被酒泉市人民医院和酒泉团市委授予“青年岗位能手”荣誉称号,在“2015年甘肃省职工技能大赛临床检验医学专业省级决赛”中荣获团体及个人一等奖,并被甘肃省总工会、甘肃省人社厅、甘肃省科技厅等五部门联合授予“甘肃省技术标兵”荣誉称号。2017年度被君安医学细胞平台管委会评为“优秀台长”。

